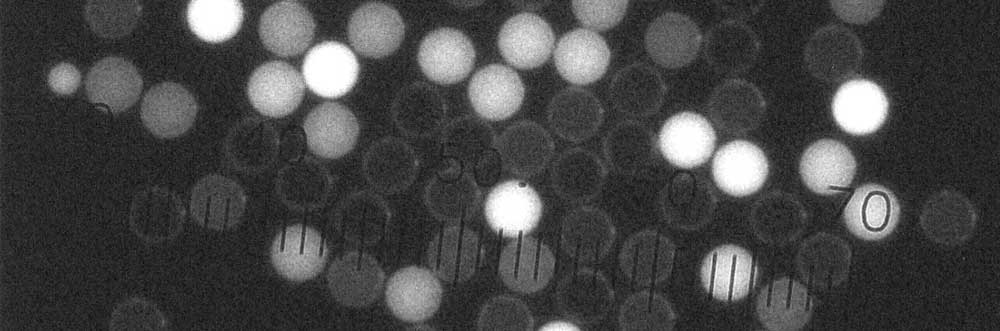
产品细节图片1

万千商家帮你免费找货
0 人在求购买到急需产品
- 详细信息
- 询价记录
- 技术资料
- 保存条件:
2-30℃
- 保质期:
5年
- 英文名:
cyto-flex microspheres
- 库存:
1ml
- 供应商:
上海辉质生物科技有限公司
- CAS号:
9003-53-6
- 规格:
1ml

Huge流式计数荧光微球具有最佳的荧光强度并在多通道 (FITC、PE、PE-Cy5)具有宽的发射光谱,用来监测流式细胞仪保持正常稳定连贯工作的最佳理想材料。我们精确的微球计数控制以及与内部染色工艺的均一性保证了流式细胞仪的检测结果具有高度可靠性。
Huge荧光微球技术参数
• 成分: 含有多重荧光染料聚苯乙烯 (Cyto-Fluorescence Polystyrene)
• 荧光颜色: 绿色荧光 (488/510 nm)与红色荧光 (545/600 nm)
• 密度: 1.05 g/cm3
• 浓度: 2500w个微粒/mL ± 5%
• 折射指数: 1.59 @ 589 nm (25°C)
| 标称直径 |
瓶装规格 |
描述 |
货号 |
| 5 µm |
1ml(可定制) |
绝对计数质控 |
FC3 |
| 7 µm |
1ml(可定制) |
绝对计数质控 |
FC7 |
风险提示:丁香通仅作为第三方平台,为商家信息发布提供平台空间。用户咨询产品时请注意保护个人信息及财产安全,合理判断,谨慎选购商品,商家和用户对交易行为负责。对于医疗器械类产品,请先查证核实企业经营资质和医疗器械产品注册证情况。
- 作者
- 内容
- 询问日期
 技术资料
技术资料需要更多技术资料 索取更多技术资料
流式计数微球
¥600









